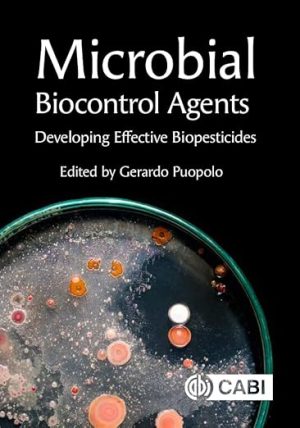
Microbial Biocontrol Agents Developing Effective Biopesticides

Entomology and Pesticides books
Showing all 21 results
-

Analysis of Pesticides in Food and Environmental Samples 2nd Edition
16,681.80 PKR Add to cart -

Biocontrol of Plant Diseases by Bacillus subtilis
16,681.80 PKR Add to cart -

Biopesticides and Bioagents
27,524.97 PKR Add to cart -

Encyclopedia of Scale Insect Pests
92,583.99 PKR Add to cart -

Handbook of HPLC 2nd Edition
16,681.80 PKR Add to cart -

Insect Diapause
18,071.95 PKR Add to cart -

Insect Pests of Potato Global Perspectives on Biology and Management 2nd Edition
48,655.25 PKR Add to cart -

Insect Pheromone Biochemistry and Molecular Biology 2nd Edition
55,606.00 PKR Add to cart -

Insects as Animal Feed Novel Ingredients for Use in Pet Aquaculture and Livestock Diets
18,071.95 PKR Add to cart -

Integrated Nematode Management State of the Art and Visions for the Future
48,655.25 PKR Add to cart -

Integrated Pest Management On Rangeland A Shortgrass Prairie Perspective
12,511.35 PKR Add to cart -

Introduction to Entomology
35,309.81 PKR Add to cart -

Key Questions in Urban Pest Management A Study and Revision Guide
6,672.72 PKR Add to cart -

Manual of Agricultural Nematology
19,184.07 PKR Add to cart -

Mass Production of Beneficial Organisms Invertebrates and Entomopathogens 2nd Edition
29,193.15 PKR Add to cart -
Microbial Biocontrol Agents Developing Effective Biopesticides
18,349.98 PKR Add to cart -

Nematodes as Model Organisms
29,471.18 PKR Add to cart -

Public Health Entomology 2nd Edition
51,991.61 PKR Add to cart -

Reproductive Strategies in Insects
29,749.21 PKR Add to cart -

Role of Mulching in Pest Management and Agricultural Sustainability
15,013.62 PKR Add to cart -

Westcotts Plant Disease Handbook 8th Edition
68,117.35 PKR Add to cart